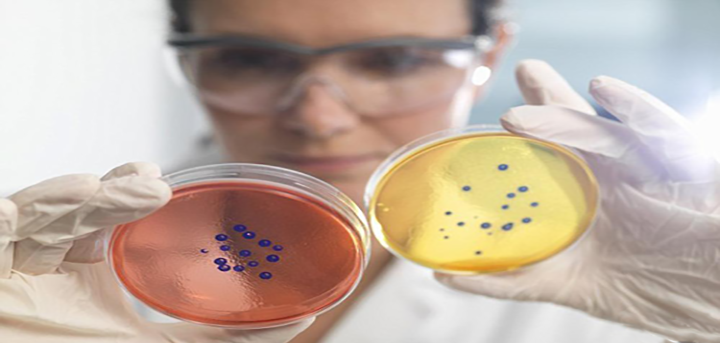

去柬埔寨做第三代试管婴儿费用是多少?大家想去做柬埔寨第三代试管婴儿 ,首先要清楚柬埔寨第三代试管婴儿的费用只能说一个范围,没有固定的数目的,因为柬埔寨第三代试管婴儿的价格受到多方面因素的影响,不同的年龄,身体状况,选择的医生方案和医院,这些都会影响到柬埔寨第三代试管婴儿的价格。
柬埔寨第三代试管婴儿费用主要分为医疗费用、生活费用以及其他费用三大部分,每个人的情况有所不同,建议您结合自己实际情况,根据身体情况和需求,做好柬埔寨试管的费用预算!
影响柬埔寨第三代试管婴儿费用的因素
1、患者年龄:女性卵巢功能好坏与使用排卵药物相比,年龄越大,药物越多,费用越高。同时,女性的年龄也是影响试管婴儿成功率的关键因素,也会增加试管婴儿的费用,所以如果是高龄去做柬埔寨试管婴儿的话,费用也会增加;
2、不孕症的原因:由于每个病人的身体状况不同,导致不孕不育的原因在术前需要进行详细的术前检查,有些妇女如果患有妇科炎症或其他疾病会影响柬埔寨试管婴儿的手术治疗,需要在手术前治愈,这部分费用会增加试管婴儿手术的费用,这些费用虽然不是直接算进医疗费用中,但也是做柬埔寨试管婴儿的时候不可避免的费用;
3、心理因素:精神状态的影响也是极其重要的,患者的心理和精神状态是影响试管婴儿治疗成功或失败的一个非常重要的因素。过度的心理紧张容易导致内分泌失调,导致胚胎难以植入,然后需要重新移植甚至再做试管,增加手术费用。
Tips:
以上就是我的解答,若有疑问或是想要了解更多柬埔寨第三代试管方面的问题,可以直接联系我们,为您讲解费用、成功率,教您身体检查和调理,提高您的试管成功率+降低试管费用!

